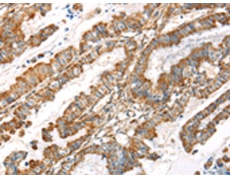
一抗

相關(guān)類別: 一抗
|
Background: |
This gene encodes a member of the lysyl oxidase gene family. The prototypic member of the family is essential to the biogenesis of connective tissue, encoding an extracellular copper-dependent amine oxidase that catalyses the first step in the formation of crosslinks in collagens and elastin. A highly conserved amino acid sequence at the C-terminus end appears to be sufficient for amine oxidase activity, suggesting that each family member may retain this function. The N-terminus is poorly conserved and may impart additional roles in developmental regulation, senescence, tumor suppression, cell growth control, and chemotaxis to each member of the family. |
|
Applications: |
ELISA, IHC |
|
Name of antibody: |
LOXL4 |
|
Immunogen: |
Synthetic peptide of human LOXL4 |
|
Full name: |
lysyl oxidase-like 4 |
|
Synonyms: |
LOXC |
|
SwissProt: |
Q96JB6 |
|
ELISA Recommended dilution: |
2000-5000 |
|
IHC positive control: |
Human esophagus cancer |
|
IHC Recommend dilution: |
25-100 |

 購物車
購物車 幫助
幫助
 021-54845833/15800441009
021-54845833/15800441009